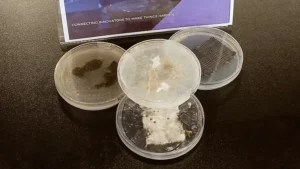

Tudomány
KITEKINTŐ: EuroNews – Forradalmi megoldást kínál a textilhulladék ellen egy lengyel vállalkozás
A Myco Renew lengyel biotechnológiai startup egy gomba alapú ruha-újrahasznosítási technológia segítségével gyorsítaná fel a textilhulladékok lebomlási idejét és méréskelné a divatipar környezetszennyező hatását. A fast fashion – az olcsó, tömeggyártáson és a legújabb trendek követésén alapuló öltözködési stílus–, mára uralja a piacot és milliók ruhatárát. Az alacsony árak és a gyakori stílusváltások azonban súlyos környzetszennyező hatással járnak.

A gombák jelentik az újrahasznosítás jövőjét? Szerzői jogok Pawel Glogowski
Az Európai Unió felismerte ezt a problémát, és olyan szabályozást vezetett be, amely előírja minden tagállam számára a ruhahulladék szelektív gyűjtésést. Az 5 éven belül hatályba lépő szabályozás szerint a felesleges darabok 50-65 százalékát újra kell majd hasznosítani.
“Becslések szerint az ember élete során körülbelül két tonna ruhát dob ki. Ez óriási probléma, hiszen a világon 8 másodpercenként 24 tonna ruhától szabadulnak meg. Ez évente 92 millió tonnát tesz ki” – mondta Tomasz Mierzwa, az újrahasznosítással foglalkozó Myco Renew nevű lengyel startup társalapítója.

Tomasz Mierzwa, a Myco Renew egyik alapítója
A zöld forradalom a gombákkal kezdődik
A cég az uralkodó trendektől eltérő megoldást javasol: az energia- és vegyszerigényes újrahasznosítási módszerek helyett egy természetes, alacsony szén-dioxid-kibocsátású kibocsátású, gomba alapú ruha-újrahasznosítási technológia alkalmazását.
“A természetes ruházat körülbelül 5 év alatt bomlik le, míg a félszintetikus 50 év alatt. A szintetikus daraboknak 200, vagy akár 1000 évbe is tellhet. Mi megmutattuk, hogy kevesebb mint 4 hét alatt képesek vagyunk lebontani ezt az anyagot” – hangsúlyozta Mierzwa.
A technológia lényege, hogy olyan gomba-alapú mikroorganizmus-közösséget hoz létre, amely lebontja a textiltdarabokat.

Természetes folyamatokat használunk. A technológiánk alacsony energiaigényű, mert a gombák elvégzik helyettünk a munka nagy részét, és a folyamat során keletkező hulladékot is felhasználhatjuk például az építőiparban szigetelőanyagként. Jeleneg egy új gombasorozatot tesztelünk, hogy metánt állítsunk elő a hulladékból
– tette hozzá az alapító.
A laboratóriumtól a teljes üzemig
A startup most azon dolgozik, hogy a laboratóriumi léptékről a technológiai készültség következő szintjére lépjen. A Myco Renew technológiája jelenleg laboratóriumi szinten van (TRL3), de az ING Bank támogatási pályázatán nemrégiben elért győzelmének köszönhetően a startup a fejlesztés következő szakaszába léphet. “A TRL4 szintre készülünk, és egy éven belül szeretnénk elindítani egy félautomata tesztvonalat. Fel szeretnénk készülni arra, amikor az uniós szabályozások öt év múlva hatályba lépnek, és hulladékfeldolgozó szolgáltatást kínálni az európai városoknak – mondta Mierzwa.

Textil újrahasznosítási folyamat fonalas gombákkal. foto: Myco Renew
“Megtanítjuk a gombákat ruhát enni”
A technológia titka az úgynevezett gombakonzorciumra – válogatott mikroorganizmusok szinergiában együttműködő csoportjára alapul. “A gombákat megtanítjuk arra, hogy a megfelelő sorrendben megegyék a különböző típusú textíliákat. Nem csak egy fajról van szó, hanem egy egész közösségről, amely rekordidő alatt bontja le a természetes és szintetikus ruhákat” – hangsúlyozta az alapító.
A technológia bemutatója a berlini divathéten. Myco Renew
A technológia bemutatója a berlini divathéten.
Az alapító szerint a technológia nem csak a hulladékiparban bizonyulhat hasznosnak. A lebomló ruhák maradékaiból ökotéglák, szigetelőanyagok vagy modern szövetek, például légáteresztő bambuszszerű anyag vagy ökobőr készíthetők. “Azt is teszteljük, hogy a hulladékot metánná alakíthatjuk, de csak miután gombáink előbb megtisztították azt a méreganyagoktól” – magyarázta Mierzwa.
Ha a ruházati ágazat versenyképes és etikus akar maradni, radikális paradigmaváltásra van szüksége: a tömegfogyasztástól a fenntarthatóság és a felelősségvállalás felé kell elmozdulnia. Európának lehetősége van arra, hogy globális irányt szabjon a jövő divatjának – amely nem áldozza fel a bolygót a szezonális öltözködési trendek oltárán.
Az idővel kiderül, hogy Lengyelország meghatározó szereplővé válik-e a divat- és hulladékgazdálkodási iparág zöld forradalmában. Egy dolog azonban biztos, a gombák többet tudnak nyújtani, mint gondolnánk.
Újságírók • Pawel Glogowski
Videószerkesztő • Pawel Glogowski
Van egy jó vadásztörténete, egy szép vadászélménye?
Küldje el az info@agrojager.hu címre
Hirdessen az Agro Jageren, Magyarország legnagyobb és legrégebbi vadászati portálján!
marketing@agrojager.hu
+36703309131
Mezőgazdaság
Befejeződik a Wagner Károly Erdészeti Digitális Szakkönyvtár 9. digitalizálási üteme
A Wagner Károly Alapítvány 207 dokumentummal, összesen 25 212 oldal terjedelemben bővítette a szakkönyvtárat.
Tavaly arról számoltunk be, hogy a 8. ütem során, 2025 májusában a Wagner Károly Alapítvány 207 dokumentummal, összesen 25 212 oldal terjedelemben bővítette a szakkönyvtárat. Újabb lépésként 2025 második felében és 2026 első felében, a 9. ütem keretében közel 25 ezer oldalnyi anyagot dolgoztunk fel:

Wagner Károly Alapítvány
Az Erdészeti Kutatások 47 kötete, előzékekkel együtt mintegy 16 500 oldal terjedelemben.
A Soproni Egyetem archív jegyzetei, mintegy 4000 oldal terjedelemben.
A Gyökerek és lombok- Erdészportrék című sorozat 12 kötete, mintegy 4500 oldal terjedelemben.
Ez azt jelenti, hogy a 9. ütem befejeztével, 2026 második felében már közel 1740 dokumentum és 348 ezer oldalnyi anyag lesz elérhető a bárki számára hozzáférhető, szabadon kereshető a Wagner Károly Erdészeti Digitális Szakkönyvtár adatbázisában.
Az Erdészeti Kutatások és az egyetemi jegyzetek
Dr. Borovics Attila, a Soproni Egyetem Erdészeti Tudományos Intézetének, az ERTI-nek a főigazgatója hozzájárulásával megkaptuk az intézet újabb kori tudományos közleményeinek, az Erdészeti Kutatásoknak 47 kötetét. Mivel a könyvtár már tartalmazza az ezt megelőzően, Erdészeti Kísérletek címmel megjelent közleményeket, a gyűjtemény a jelenlegi bővítéssel vált teljes körűen elérhetővé a nagyközönség számára.
Kiss Csabának, az Országos Erdészeti Egyesület Erdészettörténeti Szakosztálya elnökének köszönhetően 23 olyan archív egyetemi jegyzetet kaptunk meg digitalizálásra, amelyek korábban nem szerepeltek az adatbázisban. Bár a dokumentumok állapota, valamint a nehezen olvasható, kézzel írt sokszorosítások miatt néhány anyag végül nem került be a rendszerbe, így is jelentős, 4000 oldalt meghaladó anyaggal gazdagodott a szakkönyvtár.
Gyökerek és lombok. Erdészportrék
A bővítés különösen értékes eleme a Gyökerek és lombok. Erdészportrék című, 12 kötetes sorozat, amelyet Pápai Gábor, az Erdészeti Lapok egykori főszerkesztője szerkesztett. A digitalizálást Haraszti Gyula, az Erdészeti Lapok Szerkesztőbizottságának elnöke segítette elő.
A 12 kötet teljes anyagát Pápai Gábor gyűjtötte össze, az interjúkat ő készítette, és a megjelenés technikai munkálatait is ő irányította. A mintegy 4500 oldalt és 135 kiváló erdészportrét tartalmazó sorozat méltó része lett a WKDK-nak, egyúttal az Országos Erdészeti Egyesület fennállásának 160. jubileumi évére is emlékeztet. Ezúton is köszönjük Pápai Gábor önzetlen és nagylelkű segítségét.
Forrás: Wagner Károly Alapítvány – Szalga Boglárka – Indigocom
Tudomány
KITEKINTŐ: India – Nemzetközi konferencián vettek részt magyar jogászok a háziállatok és a vadon élő állatok védelmében
A Károli Gáspár Református Egyetem és a Sharda University együttműködésében kétnapos, hibrid nemzetközi konferenciát rendeztek a Sharda School of Law szervezésében.
A Károli Gáspár Református Egyetem és a Sharda University együttműködésében kétnapos, hibrid nemzetközi konferenciát rendeztek a Sharda School of Law szervezésében. A rangos tudományos eseményen a nemzetközi és összehasonlító jogi megközelítésben vizsgálták a háziállatok és a vadon élő állatok védelmének aktuális kihívásait, különös tekintettel a jogalkotás, a jogalkalmazás és az új technológiák szerepére. Az esemény súlyát mutatja, hogy a konferenciát Shri Y. K. Gupta, a Sharda Egyetem rektorhelyettese vezette, miközben Prasanna Bhalachandra Varale bíró, az Indiai Legfelsőbb Bíróság bírája is megtisztelte a konferenciát, aki találkozott a magyar kutatókkal: Prof. Dr. Szuchy Róberttel, a Károli Gáspár Református Egyetem oktatási rektorhelyettesével, valamint Prof. Dr. Domokos Andreával, a KRE Állam- és Jogtudományi Karának dékánhelyettesével, a Bűnügyi Tudományok Intézetének vezetőjével is.

Ünnepélyes keretek között vette kezdetét a konferencia. A képen jobbról a második Prof. Dr. Szuchy Róbert, a Károli Gáspár Református Egyetem oktatási rektorhelyettese. Fotó: Sharda University
2026. január 16–17. között megrendezett a Conceptualizing Legal Framework and Policies for Domestic Animal and Wildlife Conservation: Issues and Challenges című konferencia megnyitó ünnepsége hagyományos indiai szertartással – a lámpagyújtással és a Saraswati Vandanával – vette kezdetét, amely a tudás, a fenntarthatóság és az ökológiai felelősségvállalás iránti közös elköteleződést jelképezte.

Konferencia Indiában, a a Sharda School of Law szervezésében. Fotó: Sharda University
A megnyitón felszólalt többek között Prof. (Dr.) Rhishikesh Dave, a Sharda School of Law dékánja, Ms Vishaish Uppal (WWF India), Prof. (Dr.) Sibaram Khara, a Sharda University rektora, valamint Prof. Dr. Szuchy Róbert, a Károli Gáspár Református Egyetem oktatási rektorhelyettese. A felszólalók egyhangúlag hangsúlyozták a jogi keretek megerősítésének, a hatékony végrehajtásnak és a nemzetközi akadémiai együttműködésnek a jelentőségét az állat- és természetvédelem területén.
Károlis szakmai hozzájárulások: európai perspektívák
A konferencia szakmai programjában a Károli oktatói meghatározó szerepet vállaltak.

Prof. Dr. Domokos Andrea dékánhelyettes, intézetigazgató előadása közben. Fotó: Sharda University
Prof. Dr. Domokos Andrea, a KRE Állam- és Jogtudományi Karának dékánhelyettese előadásában az Európai Unió állatjóléti és állatvédelmi rendszerét mutatta be. Kiemelte, hogy az uniós jog – különösen a Lisszaboni Szerződés 13. cikke – az állatokat érző lényként ismeri el, és hogy az EU „brüsszeli hatása” globálisan is formálja az állatvédelmi standardokat. Ismertette továbbá a magyar állatvédelmi szabályozás legújabb szigorításait is.
Prof. Dr. Szuchy Róbert előadása a vadon élő állatok védelme és az energiarendszerek fejlesztése közötti jogi egyensúly kérdését elemezte. Bemutatta, miként érvényesülnek az uniós természetvédelmi irányelvek – különösen a Madár- és Élőhelyvédelmi irányelv – a megújulóenergia-projektek engedélyezése során, és milyen szerepet játszik ebben az Európai Unió Bíróságának ítélkezési gyakorlata.

Magyar professzorok indiai kollégáikkal értekeztek. Fotó: Sharda University
Technológia, jog és jövőbeli együttműködés
A konferencia egyik kiemelt szekciója az új technológiák – mesterséges intelligencia, drónok, genetikai nyomonkövetés – szerepét vizsgálta az állat- és természetvédelemben. A résztvevők egyetértettek abban, hogy a jogrendszereknek lépést kell tartaniuk a technológiai fejlődéssel, miközben biztosítaniuk kell az alapvető jogi garanciákat.
A kétnapos tanácskozást ünnepélyes záróülés zárta, amelyen Hon’ble Justice P. B. Varale, az Indiai Legfelsőbb Bíróság bírája is felszólalt. Záróbeszédében Prof. Dr. Szuchy Róbert hangsúlyozta: az állat- és vadvédelem globális kihívás, amely csak határokon átnyúló tudományos és intézményi együttműködéssel kezelhető eredményesen

A képen balról Prof. Dr. Szuchy Róbert, a KRE ÁJK oktatási rektorhelyettese Delhiben, a konferencia poszterje előtt. Fotó: Sharda University
A konferencia újabb fontos mérföldkövet jelent a Károli Gáspár Református Egyetem nemzetközi kapcsolatrendszerében, és megerősítette az egyetem elkötelezettségét a fenntarthatóság, az állatvédelem és a nemzetközi jogi párbeszéd iránt.
Forrás:
Károli Gáspár Református Egyetem
Állam- és Jogtudományi Kar

Tudomány
A természet mindig üzenetet küld a számunkra
Mikotoxinok Megjelenése a Magyarországi Dámszarvasok Táplálékláncában címmel rendeztek szakmai eszmecserét
Mikotoxinok Megjelenése a Magyarországi Dámszarvasok Táplálékláncában címmel rendeztek szakmai eszmecserét november 5-én a MATE Szent István Campusán. A speciális fókuszú konferencia célkeresztjében az élelmiszerlánc-biztonság, az állategészségügy és a reprodukciós biológia kérdései voltak.

Fotó: MATE
A MATE elkötelezett az agrár- és élettudományok, azon belül is a One Health – azaz az „Egy Egészség” – koncepciójának gyakorlati alkalmazása iránt. A szakmai nap előadásaiban taglalt tanulmányok elvezettek a humán orvostudomány határterületeire is: a dámszarvas ugyanis mintát adhat olyan biológiai markerekről, amelyek a humán egészségügyi kutatásokban is jelentőséggel bírnak, különösen a reprodukciós területeken.

Fotó: MATE
Dr. Gyuricza Csaba, a Magyar Agrár- és Élettudományi Egyetem rektora köszöntőjében a konferencia fontosságát hangsúlyozta: „A mai rendezvény témája kiváló példa az egyes szakterületek szoros szövetségére. Az ilyen konzorciumok kapcsán olyan új együttműködések kialakítását is elő tudjuk segíteni, amelyek révén a gyakorlat számára is hasznosítható, komplex eredmények feltárásához tudunk hozzájárulni. Ez a konferencia mindezek mellett arra is minta lehet, hogy hogyan lehet a One Health rendszerében gondolkodva, nem utólag, nem nyomkövető, hanem prediktív módon kutatásokat végezni.”
„Aki a természetet ismeri, szereti, az tudja, hogy a természet mindig üzenetet küld számunkra: üzen a talajon, a lombokon, a lehullott leveleken keresztül. Üzen az állatokon, a dámokon, az ő viselkedésükön keresztül. A tudománynak és a kutatóknak pedig az a feladata, hogy ezeket a jeleket és összefüggéseket észrevegyék, kivizsgálják és meghatározzák, ezzel segítve bennünket abban, hogy a természet, az állatvilág és az ember összhangját megteremtsük” – zárta beszédét Gyuricza Csaba.

Fotó: MATE
Dr. Posta Katalin, a MATE tudományos és minőségbiztosítási rektorhelyettese, a Genetika és Biotechnológia Intézet igazgatója kiemelte: „Ez az esemény egy interdiszciplináris viadukt a megoldások keresése érdekében: elindulunk a táplálékláncon keresztül megjelenő mikotoxinokkal, továbblépünk ezek különböző okozataival − ideértve a neurológiai reprodukciós fázisokra történő kihatásokat −, majd a folyamat végén mindezt egy patológus szemével is megvizsgáljuk. Éppen emiatt érzem úgy, hogy mindezen területeket tanulmányozva egy egységes, mélyreható kép alakulhat ki bennünk. A mai nap tehát mindenképpen kiemelt fontosságú, ezt bizonyítja a jelenlevők nagy száma is. Külön köszönöm azoknak a jelenlétét, akik fontosnak érezték egy olyan program megvalósulását, amely messze túlmutat a vadgazdálkodás és vadegészség területén.”

Fotó: MATE
Az előadások témakörei is a konferencia szerteágazó természetére mutattak rá:
- A klímaváltozás által előidézett fokozott mikotoxin megjelenés/kitettség megjelenése a vadfajok táplálékában.
- A patológus szemével végzett agancstő-megbetegedési vizsgálatok, a reprodukcióval kapcsolatos kihívások, valamint a neuro-endokrin hatások feltérképezése és mélyreható biológiai megértése.
- A mikrobiom szerepének bevonása, amely a legújabb tudományos irányzatokhoz kapcsolja témában jártas szakembereket.
Az előadásokat követő kötetlen tapasztalatcsere remek alkalmat biztosított arra, hogy a különböző szakterületek képviselői – az agrárbiológustól a patológusig, a genetikustól a virológuson át a klinikai szakemberig – gyümölcsöző és inspiráló párbeszédeket folytathassanak.
Forrás: MATE





